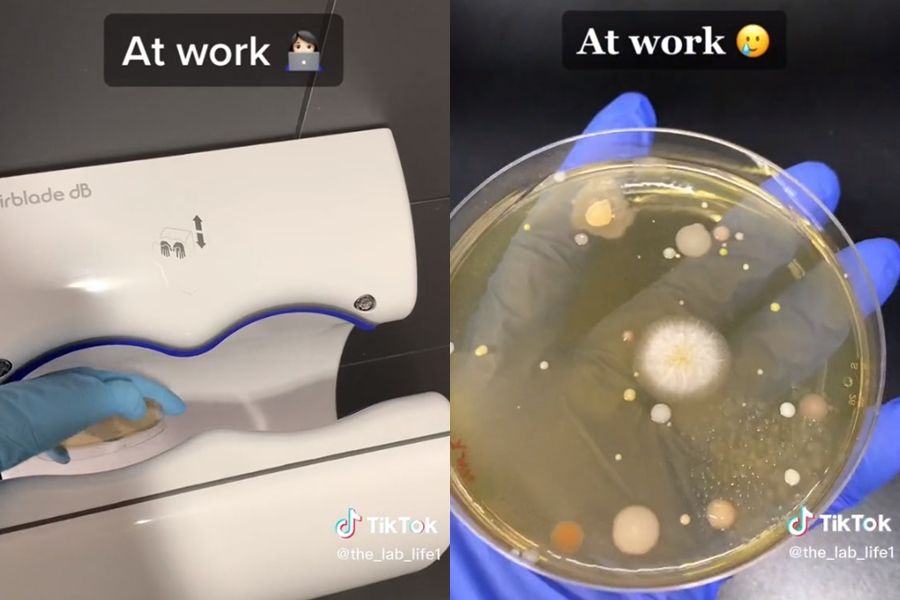
▲▼             。（圖／翻攝自TikTok）

▲ 在購物中心、電影院及工作地點採集的烘手機樣本都出現細菌。(圖/翻攝自TikTok)
記者陳宛貞/綜合外電報導
許多人洗完手會使用烘手機,除了可減少製造垃圾,也可避免地板溼答答,但實驗表明,烘手機會將空氣中的細菌透過強風吹到手上,把剛洗過的手愈吹愈髒,不僅等於白洗了,甚至可能導致疾病,因此還是選擇自然風乾或以紙巾擦乾最安全。
@the_lab_life1 Trigger warning around 50 seconds #fyp #science #lab ♬ Dog Days Are Over - Florence + The Machine
根據《每日郵報》,一名女學生經營TikTok帳號@the_lab_life1,經常上傳各種實驗影片,她分別在購物中心、電影院及工作地點採集烘手機樣本,以自然風乾的樣本作為比較,經過培養竟發現,僅自然風乾的培養皿相當乾淨,其他3個樣本都被黏稠冒泡的細菌汙染。
造成這種情形的原因不是烘手機本身充滿細菌,而是烘手機將廁所中的細菌氣溶膠吹到手上。雖然影片並未說明發現哪些細菌,但過去就有研究表明,公廁中存在流感病毒、鏈球菌、金黃色葡萄球菌、沙門氏菌、志賀氏菌及諾羅病毒。
這段影片至今累積破2330萬次觀看,網友紛紛留言表示震驚,「我每次用烘手機都想問這個」、「這就是為什麼我每次走出廁所時手都在滴水,絕對不會有人看到我用烘手機」、「那東西只會促進廁所內部空氣流動」。
2015年一項研究發現,公廁中存在超過77000種不同細菌和病毒的遺傳蹤跡,使用強力烘手機時,這些細菌就會從物體表面被吹到使用者手上。
研究人員將裝有「細菌食物」的培養皿放在沒有烘手機的廁所裡,18小時內僅長出6個病原體菌落,但用烘手機吹了短短30秒後就出現多達254個,包括可能導致敗血症、肺炎或中毒性休克症候群的金黃色葡萄球菌。
廁所空氣中大部分細菌都來自馬桶,因為每次沖水都會噴出霧狀微生物,包括糞便顆粒。因此專家仍建議,洗完手後應以紙巾擦乾。
讀者迴響